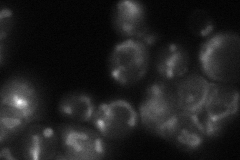
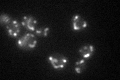

View description
Mitochondrial inner membrane protein exposed to the mitochondrial matrix, associates with mitochondrial ribosomes, NOT required for respiratory growth; homolog of human Letm1, a protein implicated in Wolf-Hirschhorn syndrome
Localization:
Intensity:
Fold change:
Significance:
-
C’ GFP library in SD

mitochondria90.11 -
N' NOP1pr-GFP in SD

mitochondria94.3019 -
N' TEF2pr-mCherry in SD

missing0 -
N' NATIVEpr-GFP in SD
mitochondria41.3233 -
N' TEF2pr-VC and Cyto-VN in SD

#N/A0 -
C’ GFP library in SD+DTT

mitochondria97.141.07No -
C’ GFP library in SD+H2O2

mitochondria102.611.13No -
C’ GFP library in Starvation Media
mitochondria61.050.67No -
C’ GFP library on the background of Pup2-DaMP

mitochondria -
C’ GFP library on the background of CCT mutant

mitochondria89.55010.993726No
